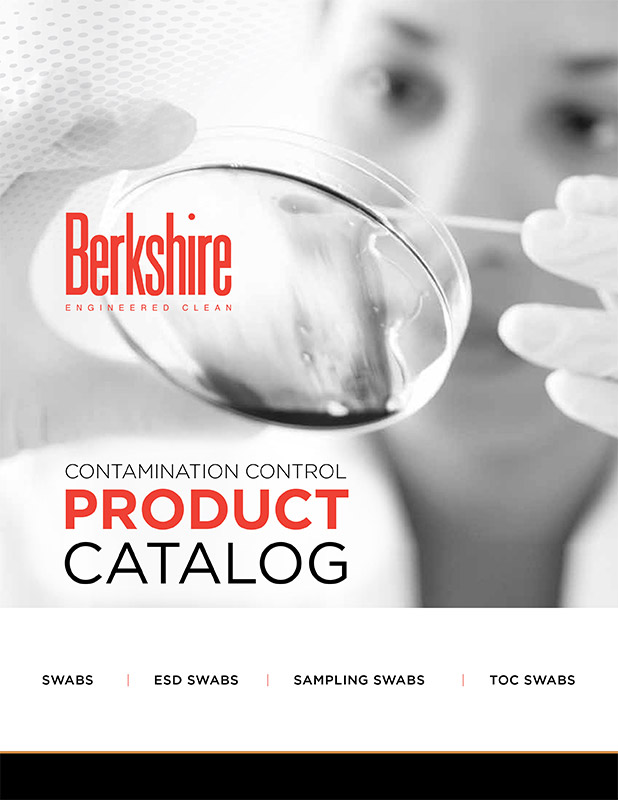

Berkshirecc Catalog
Berkshirecc Catalog - After the download has finished, you will have a PDF copy of the owner's manual saved on your device. Templates for newsletters and social media posts facilitate consistent and effective communication with supporters and stakeholders. The great transformation was this: the online catalog was not a book, it was a database. This shift has fundamentally altered the materials, processes, and outputs of design. It is a conversation between the past and the future, drawing on a rich history of ideas and methods to confront the challenges of tomorrow. Each component is connected via small ribbon cables or press-fit connectors. The work of empathy is often unglamorous. It’s about cultivating a mindset of curiosity rather than defensiveness. The Gestalt principles of psychology, which describe how our brains instinctively group visual elements, are also fundamental to chart design. In the 1970s, Tukey advocated for a new approach to statistics he called "Exploratory Data Analysis" (EDA). This particular artifact, a catalog sample from a long-defunct department store dating back to the early 1990s, is a designated "Christmas Wish Book. Furthermore, learning to draw is not just about mastering technical skills; it's also about cultivating creativity and imagination. This resilience, this ability to hold ideas loosely and to see the entire process as a journey of refinement rather than a single moment of genius, is what separates the amateur from the professional. " In these scenarios, the printable is a valuable, useful item offered in exchange for a user's email address. These are inexpensive and easy to replace items that are part of regular maintenance but are often overlooked. They are beautiful not just for their clarity, but for their warmth, their imperfection, and the palpable sense of human experience they contain. They salvage what they can learn from the dead end and apply it to the next iteration. Mass production introduced a separation between the designer, the maker, and the user. It's a way to make the idea real enough to interact with. Once your seat is in the correct position, you should adjust the steering wheel. Living in an age of burgeoning trade, industry, and national debt, Playfair was frustrated by the inability of dense tables of economic data to convey meaning to a wider audience of policymakers and the public. The images were small, pixelated squares that took an eternity to load, line by agonizing line. Principles like proximity (we group things that are close together), similarity (we group things that look alike), and connection (we group things that are physically connected) are the reasons why we can perceive clusters in a scatter plot or follow the path of a line in a line chart. A good template feels intuitive. The aesthetic that emerged—clean lines, geometric forms, unadorned surfaces, and an honest use of modern materials like steel and glass—was a radical departure from the past, and its influence on everything from architecture to graphic design and furniture is still profoundly felt today. Every new project brief felt like a test, a demand to produce magic on command. We have structured this text as a continuous narrative, providing context and explanation for each stage of the process, from initial preparation to troubleshooting common issues. 51 The chart compensates for this by providing a rigid external structure and relying on the promise of immediate, tangible rewards like stickers to drive behavior, a clear application of incentive theory. The pairing process is swift and should not take more than a few minutes. 34 By comparing income to expenditures on a single chart, one can easily identify areas for potential savings and more effectively direct funds toward financial goals, such as building an emergency fund or investing for retirement. Next, take a smart-soil pod and place it into one of the growing ports in the planter’s lid. A professional, however, learns to decouple their sense of self-worth from their work. 58 By visualizing the entire project on a single printable chart, you can easily see the relationships between tasks, allocate your time and resources effectively, and proactively address potential bottlenecks, significantly reducing the stress and uncertainty associated with complex projects. " Each rule wasn't an arbitrary command; it was a safeguard to protect the logo's integrity, to ensure that the symbol I had worked so hard to imbue with meaning wasn't diluted or destroyed by a well-intentioned but untrained marketing assistant down the line. Tangible, non-cash rewards, like a sticker on a chart or a small prize, are often more effective than monetary ones because they are not mentally lumped in with salary or allowances and feel more personal and meaningful, making the printable chart a masterfully simple application of complex behavioral psychology. We now have tools that can automatically analyze a dataset and suggest appropriate chart types, or even generate visualizations based on a natural language query like "show me the sales trend for our top three products in the last quarter. Platforms like Adobe Express, Visme, and Miro offer free chart maker services that empower even non-designers to produce professional-quality visuals. 1 Furthermore, prolonged screen time can lead to screen fatigue, eye strain, and a general sense of being drained. Thank you for choosing Ford. They are paying with the potential for future engagement and a slice of their digital privacy. One person had put it in a box, another had tilted it, another had filled it with a photographic texture. 58 This type of chart provides a clear visual timeline of the entire project, breaking down what can feel like a monumental undertaking into a series of smaller, more manageable tasks. The universe of available goods must be broken down, sorted, and categorized. This was a profound lesson for me. This hybrid of digital and physical products is uniquely modern. The next leap was the 360-degree view, allowing the user to click and drag to rotate the product as if it were floating in front of them. From the most trivial daily choices to the most consequential strategic decisions, we are perpetually engaged in the process of evaluating one option against another. By investing the time to learn about your vehicle, you ensure not only your own safety and the safety of your passengers but also the longevity and optimal performance of your automobile. The rise of the internet and social media has played a significant role in this revival, providing a platform for knitters to share their work, learn new techniques, and connect with a global community of enthusiasts. The printable chart remains one of the simplest, most effective, and most scientifically-backed tools we have to bridge that gap, providing a clear, tangible roadmap to help us navigate the path to success. Faced with this overwhelming and often depressing landscape of hidden costs, there is a growing movement towards transparency and conscious consumerism, an attempt to create fragments of a real-world cost catalog. 11 A physical chart serves as a tangible, external reminder of one's intentions, a constant visual cue that reinforces commitment. The door’s form communicates the wrong function, causing a moment of frustration and making the user feel foolish. This was a profound lesson for me. People tend to trust charts more than they trust text. 29 This type of chart might include sections for self-coaching tips, prompting you to reflect on your behavioral patterns and devise strategies for improvement. It begins with a problem, a need, a message, or a goal that belongs to someone else. Its primary function is to provide a clear, structured plan that helps you use your time at the gym more efficiently and effectively. What is the first thing your eye is drawn to? What is the last? How does the typography guide you through the information? It’s standing in a queue at the post office and observing the system—the signage, the ticketing machine, the flow of people—and imagining how it could be redesigned to be more efficient and less stressful. Online templates have had a transformative impact across multiple sectors, enhancing productivity and creativity. The amateur will often try to cram the content in, resulting in awkwardly cropped photos, overflowing text boxes, and a layout that feels broken and unbalanced. These are wild, exciting chart ideas that are pushing the boundaries of the field. Begin by taking the light-support arm and inserting its base into the designated slot on the back of the planter basin. You do not need a professional-grade workshop to perform the vast majority of repairs on your OmniDrive. It is a powerful statement of modernist ideals. A red warning light indicates a serious issue that requires immediate attention, while a yellow indicator light typically signifies a system malfunction or that a service is required. Take Breaks: Sometimes, stepping away from your work can provide a fresh perspective. Personal growth through journaling is not limited to goal setting. They are the shared understandings that make communication possible. " is not a helpful tip from a store clerk; it's the output of a powerful algorithm analyzing millions of data points. It doesn’t necessarily have to solve a problem for anyone else. Gail Matthews, a psychology professor at Dominican University, revealed that individuals who wrote down their goals were 42 percent more likely to achieve them than those who merely formulated them mentally. 36 The act of writing these goals onto a physical chart transforms them from abstract wishes into concrete, trackable commitments. We all had the same logo file and a vague agreement to make it feel "energetic and alternative. The Project Manager's Chart: Visualizing the Path to CompletionWhile many of the charts discussed are simple in their design, the principles of visual organization can be applied to more complex challenges, such as project management. We encounter it in the morning newspaper as a jagged line depicting the stock market's latest anxieties, on our fitness apps as a series of neat bars celebrating a week of activity, in a child's classroom as a colourful sticker chart tracking good behaviour, and in the background of a television news report as a stark graph illustrating the inexorable rise of global temperatures. The more I learn about this seemingly simple object, the more I am convinced of its boundless complexity and its indispensable role in our quest to understand the world and our place within it. 1 Beyond chores, a centralized family schedule chart can bring order to the often-chaotic logistics of modern family life.Catalogues Berck
제품 카탈로그 Berkshire
2015 2016 BCC Catalog by Berkshire... Flipsnack
View Catalogs Cleanroom Supplies Berkshire UK
Bienvenido 欢迎 Berkshire Publishing
Guest Post on berkshirecc.edu Boost Your SEO and Brand
BCC Catalog 20182019 by Berkshire... Flipsnack
Golf Course Berkshire Country Club
Latest News Berkshire Cricket
BCC College Catalog 20172018 by Berkshire... Flipsnack
Berkshire Community College Online Bookstore
Emblem Berkshire CC Respiratory Therapy McGill's Uniforms
BCC 20162017 College Catalog by Berkshire... Flipsnack
Emblem Berkshire CC McGill's Uniforms
Berkshire Community College Online Bookstore
BCC's 60th Anniversary Berkshire Community College
Berkshire Corporation on LinkedIn cleanroom mops catalog
Berkshire Community College Online Bookstore
Berkshire PreSaturated Wiper Catalog Berkshire Corporation
Berkshire Community College... Berkshire Community College
Berkshire Community College Massachusetts Association of Community
Berkshire Catalog Bernhardt Hospitality
Downloads Berkshire Corporation
BCC College Catalog 20142015 by Berkshire... Flipsnack
Download Our Latest Catalog Berkshire Corporation
Preview Berkshire’s 2014 Catalog Berkshire Publishing
Road Reversal on Main Campus Berkshire Community College
Berkshire Community College Main Campus Map
Berkshire Catalog by Bernhardt Hospitality Issuu
CDL Training Berkshire Community College
Request Paper Copies Of Berkshire Catalogs Berkshire Corporation
Plant Sale Catalog Berkshire Conservation District
Berkshire Mop Catalog Berkshire Corporation
Graphic Design Agency — Leland Creative Marketing
Related Post: